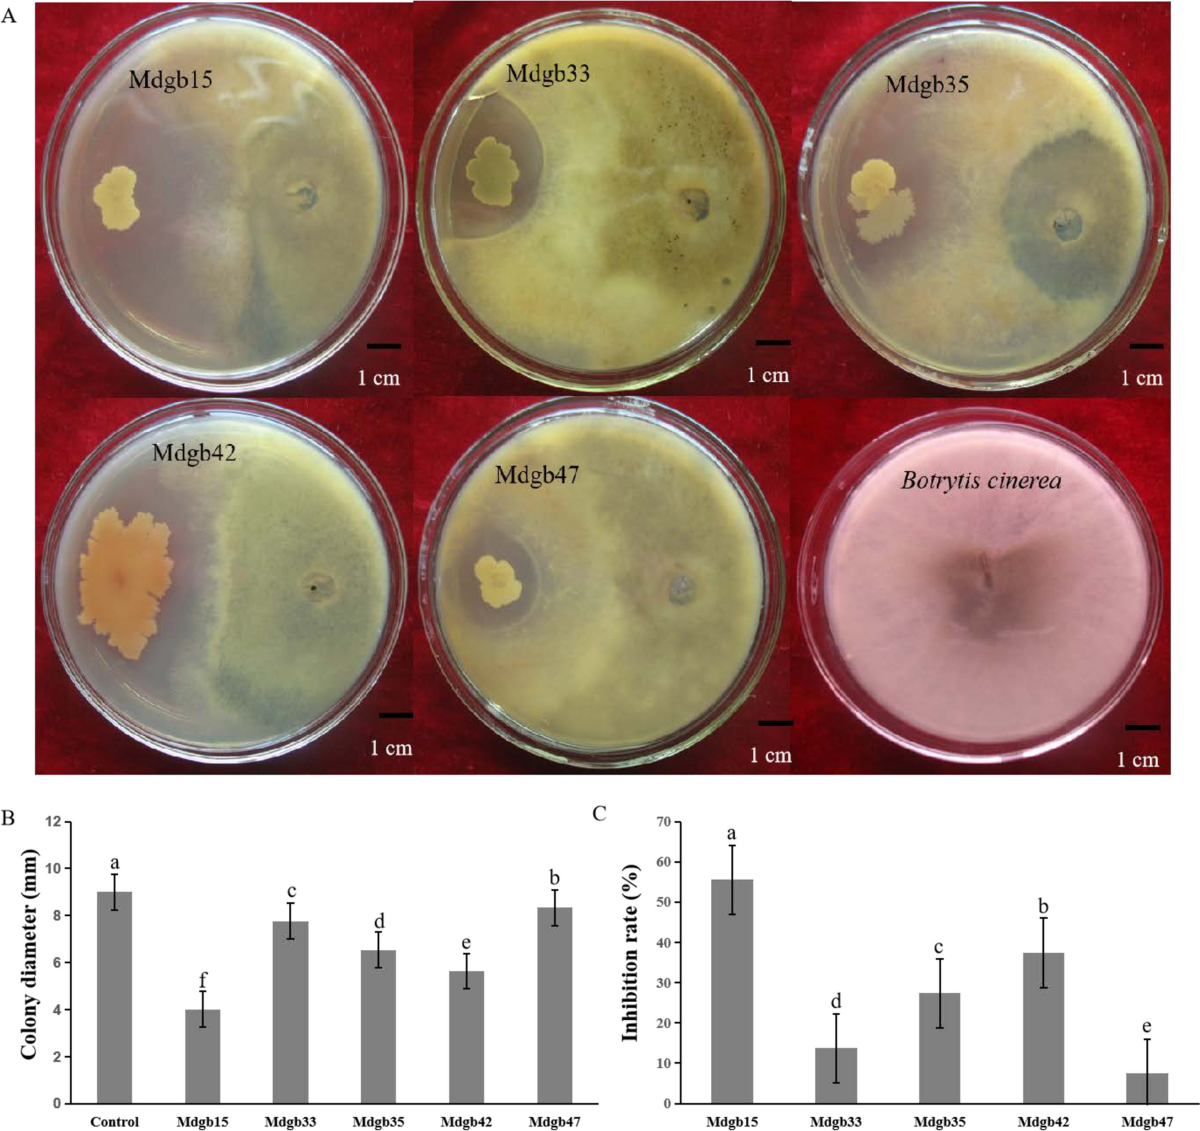
Colony reputation decay chart

Decentralized Autonomous Organizations (DAOs) are transforming collective action, enabling borderless communities to coordinate resources and make decisions without centralized oversight. Yet, as DAOs have grown in scope and value, critical challenges have emerged around voting integrity, member reputation, and the risk of concentrated power. Token-based voting systems, while simple to implement, are increasingly criticized for enabling plutocracy and exposing organizations to Sybil attacks, where malicious actors create multiple identities to manipulate outcomes. The integration of decentralized identity (DID) solutions is rapidly becoming essential for DAOs seeking robust governance frameworks that prioritize fairness, security, and meaningful participation.

Why Decentralized Identity Matters in DAO Governance
The core promise of DAOs is that they offer transparent, democratic systems where every participant has a voice. However, in practice, most DAOs rely on wallet addresses linked to token balances as the basis for voting. This approach creates two major vulnerabilities:
- Sybil Attacks: Without unique verifiable identities, individuals can control multiple wallets and artificially inflate their influence.
- Wealth Concentration: Voting power often skews toward those with the largest financial stake rather than those with the most valuable contributions or expertise.
Decentralized identity systems address these issues by enabling each DAO participant to prove their uniqueness without revealing sensitive personal data or relying on a central authority. Solutions like Hyperledger Indy and Humanity Protocol empower DAOs to verify that each vote comes from a distinct human being, dramatically reducing Sybil risks while preserving privacy.
Evolving Voting Mechanisms: From Tokens to Reputation
The shift toward DAO voting with identity wallet integration is not just about preventing fraud. It opens the door to more sophisticated voting models that reward authentic engagement over mere capital allocation. In reputation-based systems such as Colony’s platform, members earn influence through active participation, completing tasks, reviewing proposals, or contributing code, and this reputation directly informs their voting power. Unlike tokens, reputation is non-transferable and often decays over time if a member becomes inactive.
Token-Based vs. Reputation-Based DAO Governance
-

Voting Power Allocation: Token-based governance assigns voting power based on the number of tokens held, favoring those with larger financial stakes. In contrast, reputation-based governance (e.g., Colony) distributes influence according to members’ contributions and engagement, not wealth.
-

Sybil Attack Resistance: Token-based systems are vulnerable to Sybil attacks, where individuals can create multiple wallets to gain undue influence. Reputation-based models, especially those integrating decentralized identity (e.g., BrightID), verify unique participants, reducing this risk.
-

Incentivization and Participation: Token-based voting can encourage passive holding rather than active involvement. Reputation-based systems reward ongoing, meaningful participation—such as code contributions or proposal reviews—by increasing voting power for active members.
-
Transferability of Influence: In token-based DAOs, voting power is transferable via token sales, which may lead to short-term speculation. Reputation points in reputation-based DAOs are non-transferable and often decay over time, ensuring influence remains with current contributors.
-

Governance Outcomes: Token-based models can lead to centralization, with a few large holders controlling decisions (as seen in some Aragon DAOs). Reputation-based governance promotes broader community representation, aligning decisions with long-term interests and active engagement.
This evolution aligns incentives within the community by ensuring that those who contribute meaningfully have greater say in shaping the organization’s direction. It also makes onchain governance identity more resilient against manipulation by whales or external actors seeking short-term gains at the expense of long-term health.
Building Robust Reputation Systems in DAOs
A well-designed DAO reputation system does more than just allocate voting rights, it serves as a living ledger of trust within the organization. Members accumulate non-fungible reputation points for substantive actions such as technical contributions, community moderation, or successful project delivery. These points cannot be bought or sold; they must be earned through verifiable activity tracked via decentralized credentials or attestations.
This approach not only incentivizes ongoing participation but also ensures that influence remains current and relevant. For example, platforms like BrightID focus on establishing unique digital identities specifically to prevent Sybil attacks during governance events (source). By tying reputation accrual directly to these verified identities within an onchain passport or DID wallet framework, DAOs can foster meritocratic cultures where authority is continually earned rather than inherited or purchased.
As DAOs mature, the integration of decentralized identity (DID) and reputation systems becomes a critical safeguard for both security and legitimacy. These frameworks not only mitigate the risk of Sybil attacks but also ensure that the governance process reflects genuine community engagement. The Humanity Protocol, for instance, empowers portable civic identity across applications and DAOs, guaranteeing that each vote represents a real participant, not just another wallet. This level of assurance is fundamental for DAOs seeking to move beyond token-weighted plutocracy toward authentic self-sovereign DAO participation.
Implementing Onchain Governance Identity: Practical Considerations
Deploying decentralized identity within DAO ecosystems requires careful attention to privacy, interoperability, and user experience. DID wallets must support selective disclosure, allowing users to prove uniqueness or credentials without exposing unnecessary personal data. Solutions like Hyperledger Indy and BrightID offer practical pathways for integrating verifiable credentials into existing DAO infrastructure, but adoption often hinges on seamless onboarding and strong incentives for participation.
Moreover, DAOs must establish transparent criteria for reputation accrual and decay. Reputation should be tied to actions that align with organizational values: code contributions, proposal authorship, peer review, or community moderation. Decay mechanisms are essential to prevent dormant members from retaining undue influence, ensuring governance power remains dynamic and responsive.
Steps to Integrate Decentralized Identity into DAO Voting
-

Choose a Decentralized Identity Solution: Select a robust, widely-supported decentralized identity protocol such as Hyperledger Indy or BrightID to ensure unique, verifiable member identities and prevent Sybil attacks.
-

Link Identity Verification to DAO Membership: Integrate identity verification into your DAO onboarding process using platforms like Humanity Protocol or BrightID, ensuring each member is uniquely identified while maintaining privacy.
-

Implement Reputation-Based Voting Mechanisms: Adopt platforms such as Colony that support reputation-based governance, where voting power is earned through contributions rather than token holdings, promoting fairness and active participation.
-

Integrate with Non-Custodial Crypto Wallets: Require members to use established non-custodial wallets (e.g., MetaMask, WalletConnect) to interact securely with DAO voting systems and manage credentials.
-

Establish Transparent Credential Issuance and Revocation: Use verifiable credential frameworks (e.g., Hyperledger Aries) to issue, manage, and revoke identity credentials, ensuring only eligible members participate in governance.
-

Continuously Monitor and Audit Governance Processes: Regularly audit voting and identity systems using tools from platforms like Aragon to detect anomalies, ensure compliance, and maintain trust in the DAO’s governance.
Legal frameworks are also evolving alongside technical solutions. The emergence of hybrid-DAOs, blending decentralized governance with traditional legal entities, demonstrates how regulatory compliance can coexist with onchain innovation (arXiv). For organizations operating at scale or across jurisdictions, robust identity verification can facilitate KYC/AML compliance without undermining core principles of autonomy and privacy.
Future Outlook: Toward Resilient Self-Sovereign DAO Participation
The trajectory is clear: DAOs that leverage decentralized identity are better positioned to foster resilient, engaged communities where influence is earned through merit rather than wealth or manipulation. As more protocols adopt zk-SNARKs and zero-knowledge proofs within their DID wallets, privacy-preserving participation will become the norm rather than the exception.
This paradigm shift will likely accelerate as regulatory scrutiny increases and as DAOs seek legitimacy in broader economic contexts. By prioritizing unique identity verification, transparent reputation systems, and adaptive governance models, DAOs can realize their promise as truly democratic digital organizations.
Which aspect of decentralized identity is most important for DAO governance?
Decentralized identity is transforming DAO governance by improving voting fairness, boosting reputation systems, and defending against Sybil attacks. Which benefit do you think is most crucial for the future of DAOs?
For developers and founders considering these upgrades, it is crucial to evaluate available DID wallet solutions based on interoperability with leading blockchain networks, support for verifiable credentials standards (such as W3C DIDs), ease of integration with smart contracts, and ongoing community development.
Key Takeaways for DAO Builders
- Sybil resistance is foundational: Integrating DID wallets protects against manipulation by ensuring each participant is unique.
- Reputation-based voting aligns incentives: Influence should reflect actual contributions, not just token holdings.
- User privacy must be preserved: Use selective disclosure protocols so participants control what they share.
- Regulatory awareness is rising: Hybrid-DAO structures may help bridge compliance while maintaining decentralization.
The path forward lies in embracing decentralized identity as a core pillar of onchain governance. By doing so, DAOs will not only enhance their resilience but also unlock new models of collaboration grounded in trust, without sacrificing autonomy or privacy. For further reading on reputation-based voting mechanisms within DAOs, visit this detailed analysis from Colony’s team (source).
